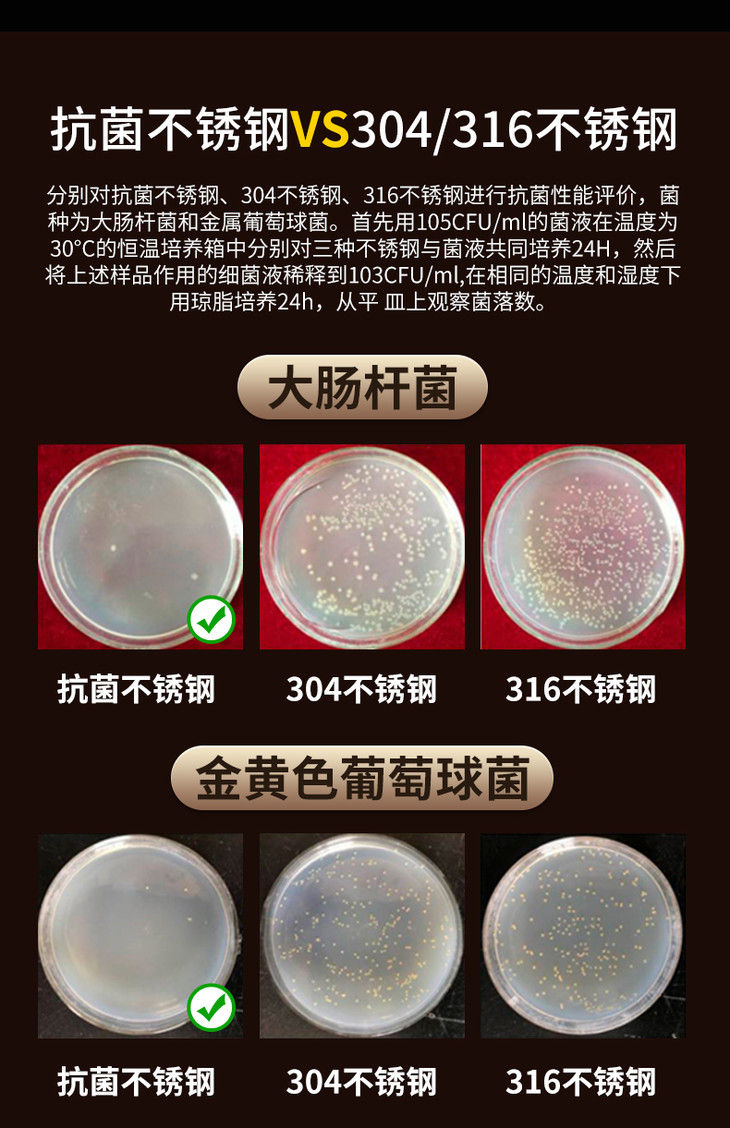

商品详情
温馨提示

云柜商城
亲爱的顾客您好:
如遇产品问题,请及时联系在线客服;
【理赔时效】48小时
【售后标准】
1.申请售后/退款必须有外包装图片,48小时内发给客服为您处理。
2.质量/产品问题请您务必拍照发送客服咨询处理哦~





















- 好物甄选平台250507250509 (微信公众号认证)
- 综合类电商平台,好吃,好玩,好用,好看
- 扫描二维码,访问我们的微信店铺
- 随时随地的购物、客服咨询、查询订单和物流...
温馨提示

云柜商城
亲爱的顾客您好:
如遇产品问题,请及时联系在线客服;
【理赔时效】48小时
【售后标准】
1.申请售后/退款必须有外包装图片,48小时内发给客服为您处理。
2.质量/产品问题请您务必拍照发送客服咨询处理哦~

微信支付
支付宝
扫一扫购买